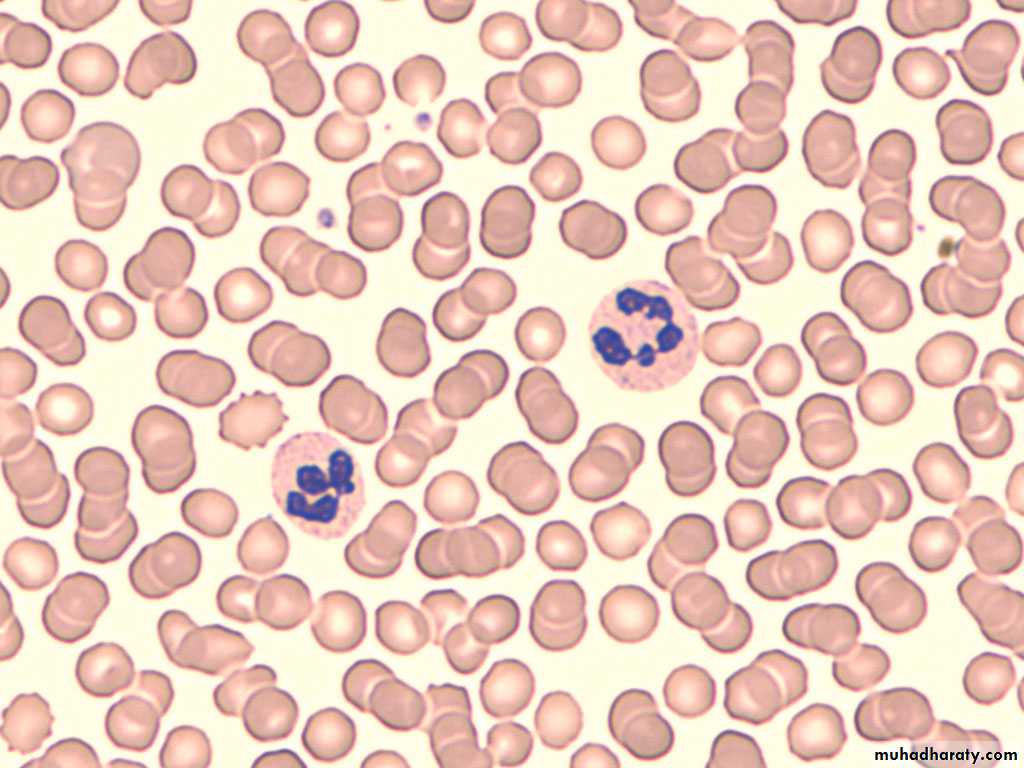
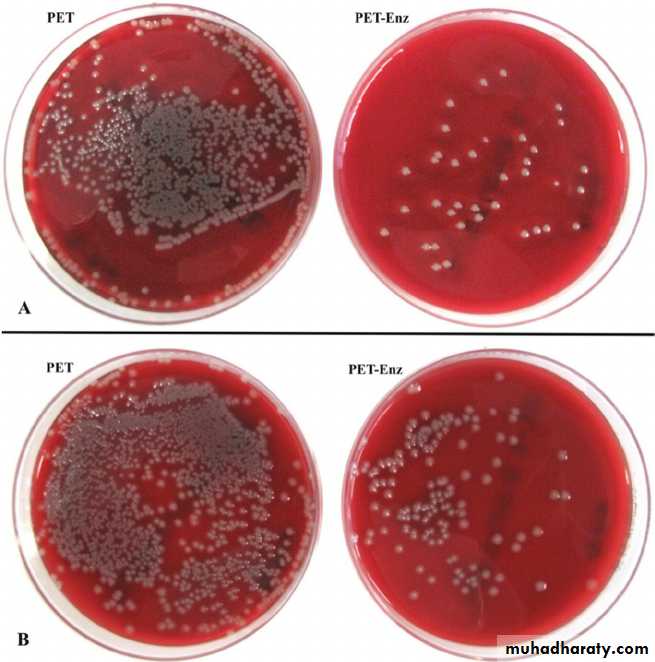

Osteomyelitis
Bone infectionBy Dr. Ihsan Alshamy
Types ( classification )according to mechanism of infection
exogenousopen fracture
Surgery
Penetrating injuries
Endogenous ( hematogenous)bacteremia in blood
According to duration of the diseaseAcute ( less than 2 weeks)
Subacute (2-3 weeks )
Chronic ( more than 3 weeks )
Acute hematogenous osteomyelitisIncidence:
88% occurs in children
(Because the children is more subjected to trauma and the developed hematoma may acts as a media for bacterial growth)
12% occurs in adults
(especially common in immune compromised adult patients )Acute hematogenous osteomyelitis
It is common around the knee jointProximal tibia and lower femur
50% around knee
Acute hematogenous osteomyelitis
It is common in the metaphysis of long bones.Pathogenesis :
1.Due to vascular stasis. The metaphysial blood vessels twist back in sharp hairpin loops pattern before it enter large sinusoidal veins, it gives time for the bacteria to escape from the vessels to the bone.
2. Relative decrease in phagocytes number in metaphysis.
pathology
Clinical features
High grade feverSwelling( signs of inflammation)
Limitation of movement ( pseudoparalyasis )
Investigation
Increase WBC count (neutrophil series)
Increase ESR
Increase C-reactive protein level
Blood culture
Positive only in 60%Bone aspirate
If purulent material is aspirated , this will confirm the diagnosis and necessitate surgical drainage and clearance .
The aspirate should be sent for :
White cell countGram stain
Culture and sensitivity
Staphylococcus aureus : 80% of cases
Streptococcus hemolyticus : 10%
Salmonella : common in patients with sickle cell anemia.
Hemophilus influenzae : common in patients below 5 years
Radiography
* Early is negative only soft tissue swelling.* After 2 weeks will shows rarefaction of the bone
* After 3 weeks new bone formation ( periosteal new bone formation )( involucrum)
Bone scan
Will shows Increase uptake of radioactive material ( hot spot).it is 90% - 95% diagnostic and positive in the first 24-48 hours.
low specificityCan not differentiates Between infection and tumor.
Management
RESTSR : rest in bed and splint to alleviate pain and prevent pathological fracture.
E : elevation of the limb.
S : systemic ( fluid and blood transfusion).
T : treatment ( antibiotics).
S : surgery
Antibiotics
* should be started according to the results of bone aspirate or blood culture
* empirical treatment should be started as early as possible according to the best guess (the most probable organism ) and modified then according to the result of culture and sensitivity test.
* The principle of treatment is initial 2-4 weeks of intravenous antibiotics , followed by 4-6 weeks of oral antibiotics.
Indication of surgery
• If there is no improvement after 36 hours from starting the conservative treatment.2 . If pus comes out during aspiration.
Surgery
Drain any subperiostial pus collection.If you don’t fined pus: open the bone either by multiple drills or by making bone window.
Complications
• Septic arthritis2. Chronic osteomyelitis.
3. Pathological fracture.
4. Epiphyseal damage and growth disturbance.
Complications
Septic arthritis
especially in intraarticular metaphyses ( sholder , elbow , hip)
Complications
Pathological fractureComplications
Chronic osteomyelitis( persistant discharging sinus and bone sequestra )